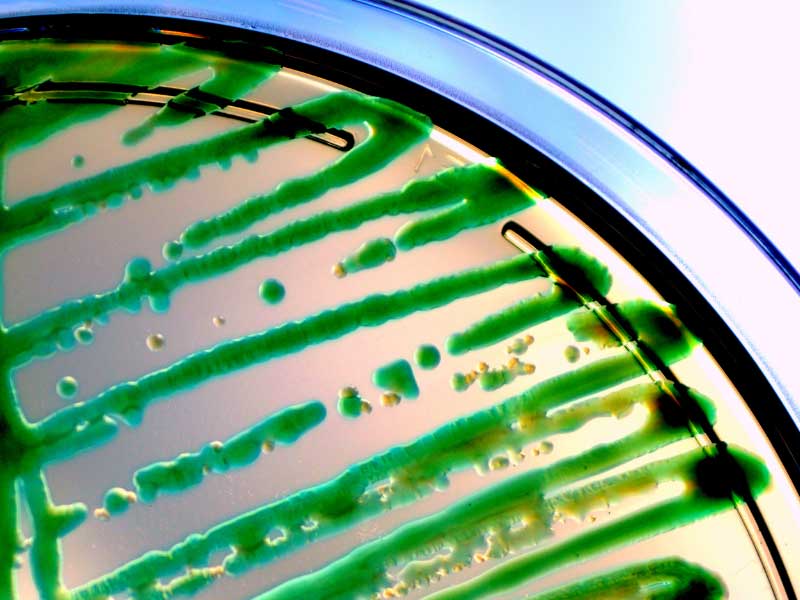

.jpg)
Mới đây, Bộ Y Tế - Viện dịch tễ trung ương đã công bố kết quả kiệm định khả năng khử trùng, khử khuẩn của nước HOCL. Kết quả cho thấy nước HOCL có khả năng diệt 99,9% trong vòng dưới 1 phút ngay cả với bào khuẩn tử "sống dai" nhất là Bacillus subtilis.

Bộ Y Tế - Viện dịch tễ trung ương công bố kết quả kiểm nghiệm khả năng khử trùng, khử khuẩn của nước HOCL. Kết quả nước HOCL có khả năng diệt 99,9% trong vòng dưới 1 phút.
Bạn cũng có thể tham khảo thêm khả năng diệt khuẩn, diệt vi trùng, nấm, virus của nước HOCL được Nhật Bản kiểm định và công bố TẠI ĐÂY
1. Staphylococcus aureus - S. aureus ( Khuẩn tụ cầu vàng)

Nếu ăn phải nguồn thực phẩm có nhiễm tụ cầu rất dễ bị ngộ độc thức ăn. Vi khuẩn này thường xâm nhập vào thực phẩm khi quá trình chế biến và bảo quản không đảm bảo vệ sinh.
- Nhiễm khuẩn da
Vi khuẩn tụ cầu vàng có thể sống ký sinh trên da và niêm mạc sau đó xâm nhập vào cơ thể thông qua lỗ chân lông, các tuyến dưới da và nang lông. Tiếp sau đó, chúng gây ra tình trạng nhiễm khuẩn kèm mủ với triệu chứng khởi phát là sự xuất hiện của mụn nhọt, chốc lở và các ổ áp xe trên da.
Bệnh do tụ cầu gây nên ở da thường do môi trường bên ngoài xâm nhập vào. Thường thì chúng ít gây bệnh nếu chỉ cư trú trên da. Tuy nhiên, khi có vết thương hở, mụn kèm theo vệ sinh kém, đề kháng yếu thì chúng sẽ có cơ hội gây nên các bệnh nguy hiểm.

Có nghiên cứu chỉ ra rằng nhiễm khuẩn tụ cầu vàng (qua thức ăn, thực phẩm, ngoài da) làm trầm trọng hơn các bệnh ngoài da như chàm, eczema... ở trẻ.
Xem thêm tại đây: https://www.jacionline.org/article/S0091-6749(19)30611-6/fulltext
- Nhiễm khuẩn huyết
Khi xâm nhập vào cơ thể, vi khuẩn tụ cầu vàng có thể gây nhiễm khuẩn máu - một tình trạng nhiễm trùng nặng. Vi khuẩn này có thể đi tới các cơ quan nội tạng và gây ra các ổ áp xe tại đây đe dọa đến tính mạng con người. Ngoài ra, bệnh còn có nhiều biến chứng nguy hiểm khác như: nhiễm khuẩn đường hô hấp, nhiễm khuẩn hệ thần kinh trung ương,...
- Nhiễm khuẩn bệnh viện
Môi trường bệnh viện luôn có vi khuẩn tụ cầu vàng, chúng có thể gây nên nhiễm trùng, điển hình như: nhiễm trùng vết bỏng, vết mổ, nhiễm trùng đường hô hấp. Không những thế chúng còn có khả năng xâm nhập vào cơ thể thông qua các thủ thuật hoặc can thiệp y khoa. Vết thương hở cũng là con đường thuận lợi cho vi khuẩn xâm nhập vào cơ thể. Đa số trường hợp nhiễm khuẩn tụ cầu vàng tại bệnh viện thường xảy ra với bệnh nhân nằm viện dài ngày.
- Hội chứng sốc nhiễm khuẩn
Mặc dù rất hiếm gặp nhưng hội chứng này có tính đột ngột và dễ gây nguy hiểm cho người bệnh khi vi khuẩn tụ cầu vàng phát triển quá mức và giải phóng độc tố. Người bệnh thường xuất hiện các triệu chứng như: hôn mê, thở nhanh nông có thể có những cơn ngừng thở, mạch nhanh nhỏ và khó bắt, huyết áp tụt, chân tay lạnh, tiểu ít hoặc vô niệu,...
Trong môi trường tự nhiên, Pseudomonas aeruginosa có thể sống trong đất, trong đầm lầy và đặc biệt là môi trường ven biển, chúng tồn tại trong điều kiện mà ít sinh vật nào có thể chịu được.
Trực khuẩn mủ xanh gây nhiều bệnh nguy hiểm.
Pseudomonas aeruginosa thường tồn tại nhiều trong môi trường bệnh viện, chúng có thể được tìm thấy trong các dụng cụ y tế, sàn nhà, tường, giường bệnh và có thể có trên tay của các cán bộ y tế. Từ đó, vi khuẩn dễ lây lan, xâm nhập vào bệnh nhân và gây bệnh, đặc biệt là những bệnh nhân bệnh nhân mắc các bệnh lý ác tính, giảm bạch cầu, bệnh nhân bị suy giảm miễn dịch, bị bỏng hoặc dùng các loại thuốc ức chế miễn dịch kéo dài. Ngoài ra Trực khuẩn mủ xanh có thể sinh sôi trong các loại thuốc nhỏ mắt, thuốc gây mê, xà phòng, bồn rửa, thiết bị hồi sức, nhiên liệu, nơi ẩm ướt và thậm chí ở trong nước cất.
Pseudomonas aeruginosa khi vào trong cơ thể có thể gây nhiễm khuẩn tiết niệu, nhiễm khuẩn đường hô hấp dưới, viêm màng não, viêm màng trong tim, viêm tai giữa,...Trong đó có nhiễm trùng máu, là loại nhiễm trùng có tỷ lệ tử vong rất cao.
Tùy thuộc vào từng loại nhiễm trùng do vi khuẩn gây ra mà có các triệu chứng khác nhau.
- Nhiễm trùng máu do Pseudomonas aeruginosa gây ra các triệu chứng như sốt, ớn lạnh, nhức mỏi cơ thể, đau đầu nhẹ, nhịp tim nhanh, thở nhanh, buồn nôn, nôn, tiêu chảy, giảm đi tiểu.
- Bệnh nhân bị viêm phổi do trực khuẩn mủ xanh gồm các triệu chứng như sốt, ớn lạnh, khó thở, ho, đôi khi có chất nhờn màu vàng, xanh lá cây hoặc máu.
- Bệnh nhân muốn đi tiểu thường xuyên, khi tiểu bệnh nhân cảm giác đau buốt, nước tiểu có màu và có mùi khó chịu, đây là các triệu chứng thường thấy khi bị nhiễm trùng đường tiết niệu do Pseudomonas aeruginosa.
- Đối với những vết thương hở, trực khuẩn mủ xanh sẽ khiến vết thương bị nhiễm trùng, gây cảm giác đau, tấy đỏ, chảy dịch ở vết thương. Nếu tình trạng nhiễm trùng này kéo dài, không được điều trị, trực khuẩn mủ xanh có thể xâm nhập vào máu và gây nhiễm khuẩn huyết cho bệnh nhân.
- Đối với trường hợp nhiễm trùng tai giữa bệnh nhân có thể có các triệu chứng như đau tai, mất thính lực, chóng mặt và mất phương hướng.
Cách phòng ngừa trực khuẩn mủ xanh
- Giữ gìn vệ sinh cá nhân, nhà cửa, nguồn đất, nguồn nước sinh hoạt,...
- Đảm bảo môi trường bệnh viện luôn sạch sẽ, thoáng mát, thực hiện nghiêm túc các quy trình khử trùng, tiệt trùng định kỳ.
- Thực hiện đúng các thao tác vô trùng để tránh nhiễm chéo bệnh viện.
- Nạn nhân bị bỏng nặng nên đưa vào phòng cách ly để hạn chế tối đa tiếp xúc với các tác nhân gây bệnh tiềm ẩn.

Vi khuẩn E.Coli - nguyên nhân phổ biến gây tiêu chảy, ngộ độc thực ăn ở người
- Phổ biến nhất là tiêu chảy hay còn gọi là nhiễm độc thức ăn: Người bệnh có biểu hiện sốt, tiêu chảy, nôn. Biến chứng nặng xảy ra thường là do tiêu chảy nhiều mà không được bù dịch kịp thời dẫn đến trụy mạch, rối loạn tuần hoàn, suy thận...
- Nhiễm khuẩn huyết là khi vi khuẩn này xâm nhập vào đường tiêu hóa rồi tiếp tục xâm nhập vào các mạch máu trong cơ thể làm tổn thương các tạng lân cận như tim, thận, não khiến người nhiễm E. Coli có thể tử vong.
- Nhiễm khuẩn đường tiểu do vi khuẩn E. coli, đi từ bộ phận cuối cùng của đường tiêu hóa là hậu môn sang lỗ tiểu ngoài, đi ngược dòng vào đường niệu. Hoặc là vi khuẩn E. Coli gây nhiễm khuẩn huyết và vi khuẩn từ máu bệnh nhân đi khắp cơ thể, đến đường niệu và gây nhiễm khuẩn đường tiểu.
- Viêm màng não và các nhiễm khuẩn khác trong hệ thống tiêu hóa.
Ngoài ra vi khuẩn E. Coli cũng có một số vai trò nhất định trong cơ thể người như: Ngăn chặn sự tấn công của vi khuẩn xâm nhập vào đường tiêu hóa, Kích thích hệ miễn dịch của cơ thể, Sản xuất các chất có lợi cho cơ thể: vitamin K, biotin, Chuyển hóa chất đường trong cơ thể...
Uống nước ô nhiễm
Một trong những nguyên nhân gây ô nhiễm nguồn nước đó là do phân người và động vật, chính vì thế nước ở khu vực sông, hồ, ao, giếng có khả năng ô nhiễm tương đối cao. Nguồn nước tại đây thường không được khử trùng sạch sẽ bằng hệ thống hiện đại. Nếu người dân sử dụng chúng, rất có thể họ sẽ bị nhiễm khuẩn e coli.
Ăn các loại thực phẩm ô nhiễm
Thực phẩm rất dễ bị ô nhiễm bởi vì chúng ta chưa biết cách sơ chế hoặc bảo quản chúng trong điều kiện nhiệt độ, độ ẩm thích hợp. Việc uống sữa chưa tiệt trùng, không ăn chín, uống sôi hoặc ăn các loại gia súc, gia cầm nhiễm bệnh có thể tăng nguy cơ nhiễm vi khuẩn e coli.
Bên cạnh hai nguyên nhân kể trên, vi khuẩn cũng có thể lây nhiễm từ người sang người hoặc từ động vật sang người. Đặc biệt, trong trường hợp bạn tiếp xúc trực tiếp với nguồn lây nhiễm bệnh. Chính vì thế, chúng ta cần đảm bảo vệ sinh sạch sẽ cho bản thân và những người xung quanh.
Bacillus subtilis là lợi khuẩn tự nhiên có ở hệ vi khuẩn đường ruột con người.

Lợi khuẩn Bacillus subtilis.
Trong điều kiện không thuận lợi, B. subtilis thường tồn tại ở trạng thái bào tử, có lớp vỏ khá dày và cứng chịu đựng được điều kiện môi trường khắc nghiệt.
Bacillus subtilis có khả năng chịu được pH thấp, có khả năng chịu nhiệt (ở 100oC trong 180 phút), chịu ẩm, tia tử ngoại, tia phóng xạ, áp suất, chất sát trùng, có thể sống vài năm đến vài chục năm. Đây là một trong những loại bào tử khuẩn mạnh mẽ và "sống dai" nhất.
Viện dịch tễ đã lấy lợi khuẩn này để kiểm tra khả khăng khử khuẩn tuyệt vời của nước HOCL. Nước HOCL dễ dàng loại bỏ 99,9% khuẩn Bacillus subtilis chưa đầy 1 phút.
Thông thường, nấm candida sẽ sống cân bằng với các vi sinh vật khác trên cơ thể mà không gây tác hại gì. Tuy nhiên, khi gặp các điều kiện thuận lợi, nấm candida sẽ có cơ hội phát triển mạnh và gây bệnh ở nhiều bộ phận khác của cơ thể. Tùy vào vị trí bị nhiễm nấm mà các biểu hiện bệnh sẽ khác nhau.

Candida albican.
Những bệnh do nhiễm trùng nấm candida gây ra
- Bệnh tưa miệng: bệnh tưa miệng là tên gọi chung của bệnh nhiễm trùng miệng do nấm Candida albican. Nấm sẽ ảnh hưởng đến các bề mặt ẩm quanh môi, bên trong má, trên lưỡi và vòm miệng.
- Viêm thực quản: nấm candida từ miệng có thể lan sang thực quản, gây viêm thực quản.
- Nhiễm nấm candida ở da: những vùng da thường bị nhiễm nấm là những vùng da ít thông thoáng, hay ẩm ướt như: bàn tay của những người thường xuyên đeo găng tay, vành da ở gốc móng tay ở những người thường xuyên tiếp xúc với nước, khu vực da quanh háng, các nếp nhăn ở mông và các nếp da dưới ngực.
- Nhiễm nấm candida âm đạo là một viêm nhiễm phụ khoa thường gặp. Có trên 75% phụ nữ bị nhiễm nấm candida ít nhất một lần trong đời. Nguy cơ nhiễm nấm candida âm đạo sẽ tăng lên nếu phụ nữ đang có thai hoặc mắc bệnh tiểu đường.
- Nhiễm nấm candida toàn thân: nấm candida có thể xâm nhập vào máu qua vị trí mở khí quản, ống thông khí hoặc vết thương phẫu thuật làm nhiễm trùng máu, từ đó lây lan khắp cơ thể, gây nhiễm trùng nặng. Bệnh thường xảy ra ở trẻ sơ sinh có trọng lượng thấp và những người có hệ miễn dịch suy yếu nghiêm trọng.
- Các bệnh do nhiễm nấm candida gây ở da, vùng miệng, thực quản và vùng sinh dục tuy gây ra các triệu chứng khó chịu nhưng thường dễ điều trị và ít khi đe dọa tính mạng. Tình trạng nghiêm trọng là khi nấm candida xâm nhập vào máu gây nhiều biến chứng nguy hiểm, đây là một tình trạng khẩn cấp cần được can thiệp kịp thời.
Phòng ngừa bệnh Nhiễm nấm Candida (nhiễm trùng nấm men)
- Giữ cho da sạch và khô, tránh mặc quần áo bó sát hoặc đồ lót quá chật. Giữ cho âm đạo luôn sạch và khô thoáng, vệ sinh âm đạo bằng dung dịch vệ sinh phù hợp, chỉ vệ sinh vùng sinh dục ngoài, thụt rửa sâu bên trong âm đạo có thể làm tăng nguy cơ nhiễm nấm candida hoặc làm tình trạng nhiễm nấm trầm trọng thêm.
- Giữ gìn vệ sinh răng miệng tốt: đánh răng hai lần mỗi ngày, súc miệng và họng bằng nước muối ấm, thường xuyên thay bàn chải đánh răng, không dùng chung bàn chải đánh răng với người khác.
- Sử dụng kháng sinh theo hướng dẫn của bác sĩ.
- Kiểm soát tốt đường máu, đặc biệt ở những bệnh nhân bị đái tháo đường.
- Thực hiện lối sống lành mạnh, dinh dưỡng hợp lý, tập luyện thể dục thể thao để nâng cao thể lực.